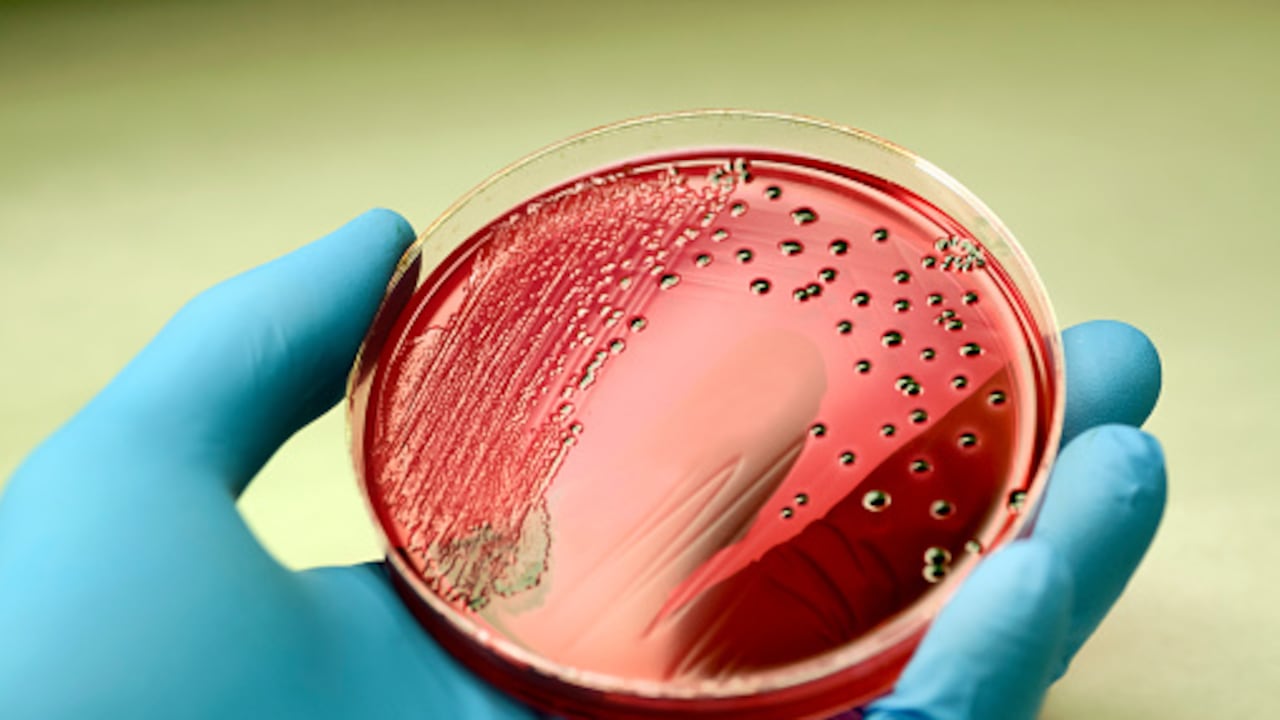
La salmonela, en algunos casos, puede provocar la fiebre tifoidea, una enfermedad potencialmente mortal si no recibe tratamiento adecuado.

Recientemente, el Ministerio de Salud de la Nación y de Salud Pública de la ciudad de Salta, en Argentina, emitió una alerta epidemiológica por el aumento de casos de fiebre paratifoidea (causada por la salmonela), según informó el diario La Nación.

Autoridades sanitarias de Salta detallaron que más de 60 % de los afectados por la fiebre paratifoidea son menores de 15 años y, en su mayoría, residen en esa ciudad argentina.
Al mismo tiempo que el mundo continúa la batalla contra la pandemia de la covid-19, el brote de fiebre paratifoidea disparó una alerta en Argentina para extremar los cuidados y evitar el contagio de esta enfermedad.
Según la Organización Mundial de la Salud (OMS), la fiebre tifoidea y paratifoidea es una enfermedad infecciosa potencialmente mortal causada por la bacteria salmonela typhi, que suele transmitirse por agua o alimentos contaminados.
Si algo ha aprendido la humanidad con el coronavirus es que ninguna enfermedad infecciosa puede subestimarse, por lo que es importante conocer qué tipo de bacterias existentes significan un riesgo para la salud y cómo se pueden prevenir.
De acuerdo con el portal médico Mayo Clinic, la infección por salmonela (salmonelosis) es una enfermedad bacteriana que afecta el aparato intestinal, y puede llegar al organismo mediante el consumo de alimentos contaminados. Esta bacteria, generalmente, vive en los intestinos de animales y humanos, y se libera mediante las heces.
El portal médico también detalla que, por lo general, las personas que se infectan con salmonela no presentan síntomas, sin embargo, hay quienes manifiestan diarrea, fiebre y calambres abdominales dentro de las ocho a 72 horas posteriores a la infección.
Es importante no subestimar los síntomas y recibir atención especializada para evitar que la infección evolucione. Por ejemplo, la diarrea asociada a la salmonela puede derivar en casos de deshidratación; de igual manera, si se extiende más allá de los intestinos, las consecuencias serían de mayor gravedad.

¿Cómo detectarla?
El periodo de incubación de la salmonela varía entre un par de horas a dos días. Una vez la infección ha madurado, puede generar síntomas como náuseas, vómitos, calambres abdominales, diarrea, fiebre, escalofríos, dolor de cabeza y sangre en las heces.
Según detalla el portal médico Mayo Clinic, los síntomas producidos por la infección duran de dos a siete días, aunque los intestinos regresarían a la normalidad hasta después de varios meses.
Como en el caso que se presentó en Salta, Argentina, existen variedades de salmonela que provocan fiebre tifoidea o paratifoidea, una enfermedad que puede ser mortal si no se recibe el tratamiento adecuado.
Así llega la infección por salmonela
Si bien la bacteria salmonela vive en el intestino de los seres humanos, esta se expulsa en las heces. Así ocurre también en los animales. Para que una persona se contagie de salmonela, según explica Mayo Clinic, una posibilidad es haber ingerido alimentos contaminados.
1. Carne cruda: aplica para todos los alimentos de origen animal, ya sean carnes rojas, pollo o pescado. Durante el proceso de matanza, las heces pueden llegar a la carne y contaminarla.
Los peces, por ejemplo, también pueden contener la bacteria si se obtienen de agua contaminada.
2. Huevos crudos: en general, cualquier alimento de origen animal que esté crudo o mal cocido podría representar un riesgo de adquirir salmonela. En el caso del huevo, si la gallina está infectada, sucederá lo mismo con este.
3. Frutas y vegetales: si los vegetales o frutas son lavados con agua contaminada, estos adquirirán la bacteria. De igual modo, el riesgo se eleva si entran en contacto con jugos de carne cruda o heces de animales.
Si la infección por salmonela no recibe el tratamiento adecuado, podría suscitar complicaciones como la deshidratación y su expansión por el torrente sanguíneo, afectando los tejidos en todo el cuerpo.